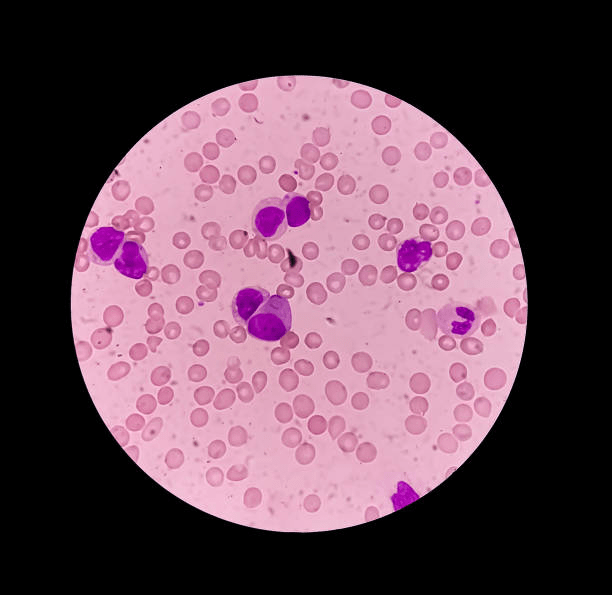
best surgical oncologist in Gurgaon

Leukemia awareness- Everything that you need to know
The National Cancer institute dictates that around 1.6% of every individual may face leukemia at least once in their lifetime. This cancer is known for its remission. In other words, no matter how many times you cure cancer, it shows chances of relapse. Due to its onset, again and again, it results in making the person go through unnecessary tribulations and anxiousness.
Leukemia is a type of blood cancer and requires a lot of knowledge and updates so that its prevention and cure can remain an option for you. Without knowing much about any disease, you will feel more helpless and out of place. Although the best oncologist in Gurgaon will help suffice your needs yet it is mandatory to keep yourself aware and vigilant about life-threatening diseases like cancers.
What are the different types of leukemia?

The uncontrollable division of blood cells, especially the white blood cells that help fight against different infections, are the significant targets of leukemia. The outcome is such that there are abnormal hiking counts of the white blood cells leading to their inappropriate functioning.
Leukemia can either be classified into acute or chronic.
Acute leukemia-
In this disease, there is the sudden uncontrollable differentiation of the white blood cells. This type of leukemia proceeds at a dangerous rate and is fatal to health.
Chronic leukemia-
Symptoms are not detected very quickly in this kind of leukemia. The spread of the disease is slow, and diagnosis of the disease can be made through a regular blood evaluation. This disease gradually increases, leading to worsened symptoms at a later period.
Further classification can be done based upon the cells in which cancer occurs. This may be either the lymphoid cells or the myeloid cells.
Thus, summing up, the four most common types of leukemia are listed down below;
The risk factors of leukemia-
The risk factors of each disease constitute several points that should be taken care of. These factors are the solely responsible reasons for which the disease may afflict you. Hence, if you can control or find the solution to mitigate these risk factors, you will, in a way, also alleviate the chances of your acquiring the disease.
Nevertheless, it should be kept in mind that there are instances where a person may get the disease even when he shows no known risk factors. However, this is an important indicator that may help you in preventing cancer. The risk factors of leukemia are listed down below; you can tally with the points and contact an oncologist in Gurgaon if you anticipate that you may be a candidate for cancer. Know that the best oncologist in Gurgaon, India, will do all that is in his capabilities to help you overcome the situation.
The signs and symptoms of leukemia-
Visit your doctor immediately if you notice any of the following listed symptoms. You must notify him of any abnormalities so that he can make you undergo the necessary tests and thus evaluate your health status.
The signs that you should keep a close look upon are;
The next step after detecting the symptoms is to immediately reach your health care provider so that he can plan the further steps. The following immediate action to be taken is a patient evaluation to know your current health status. The tests include biopsy, blood examination, spinal tap, chest X-ray, bone marrow aspiration, etc.
Cancer is a complex disease; therefore, the treatment plan is also extensive. At times, the treatment involves a combination of procedures to work together so that a favorable outcome is obtained. The different cancer therapies include chemotherapy, radiation, targeted therapy, immunotherapy.
The best cancer doctor in Gurgaon will consider a host of factors like the age of the patient, overall health status, and if leukemia was found in the cerebrospinal fluid.
Aggressive cancers have very potent treatment planning; therefore, traditional side effects are typical citings. There are a set of medications and supportive therapy given in case of the side effects faced by patients. It is to be noted that the doctors do a comprehensive study before choosing the suitable treatment for you. Thus, even if there are side effects to the treatment, it should be known that the benefits outweigh the disadvantages.
While treating the cancer disease, all you need to do is to maintain vigilance and have the upper hand over cancer by knowing the risk factors, symptoms, and signs so that you can go up to your doctor at the earliest to knock off the disease and remove the traces of cancer from the roots.
For the best-guided cancer treatment, you can always rely on Dr. Kaushal Yadav, who is the best oncologist in Gurgaon, to help you and motivate you throughout the way.

Contact the best Cancer doctor in Gurgaon!

Dr. Kaushal Yadav is an extensively trained cancer surgeon in Gurgaon, India with exceptional skills. An alumini of MS (Surgery) from PGIMS, Rohtak, Haryana, India. Presently he is working as Senior Consultant Surgical Oncology at Narayna Superspeciality Hospital, Gurugram.

